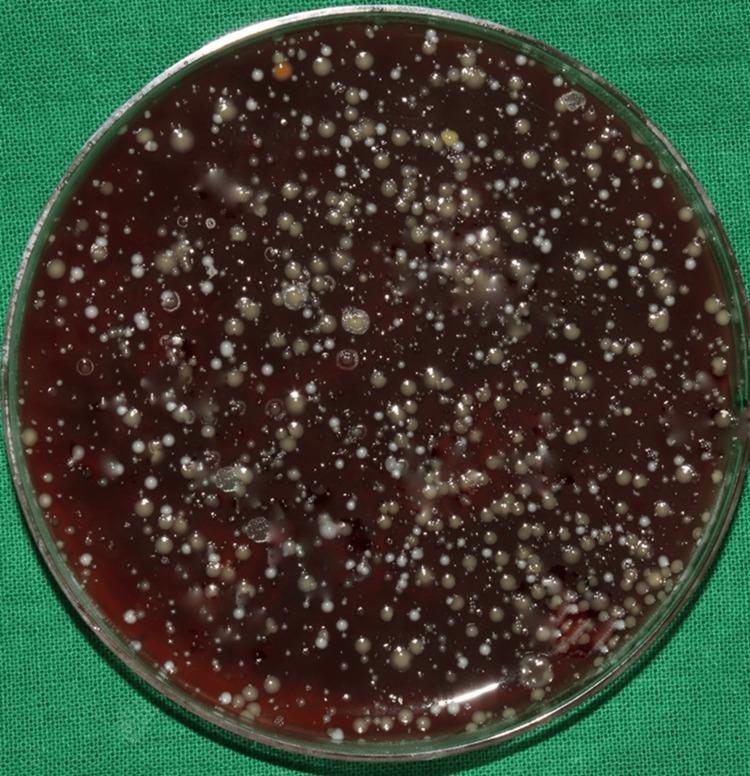
https://cdn.ncbi.nlm.nih.gov/pmc/blobs/78d4/10733898/1573e23f376d/cureus-0015-00000049164-i03.jpg
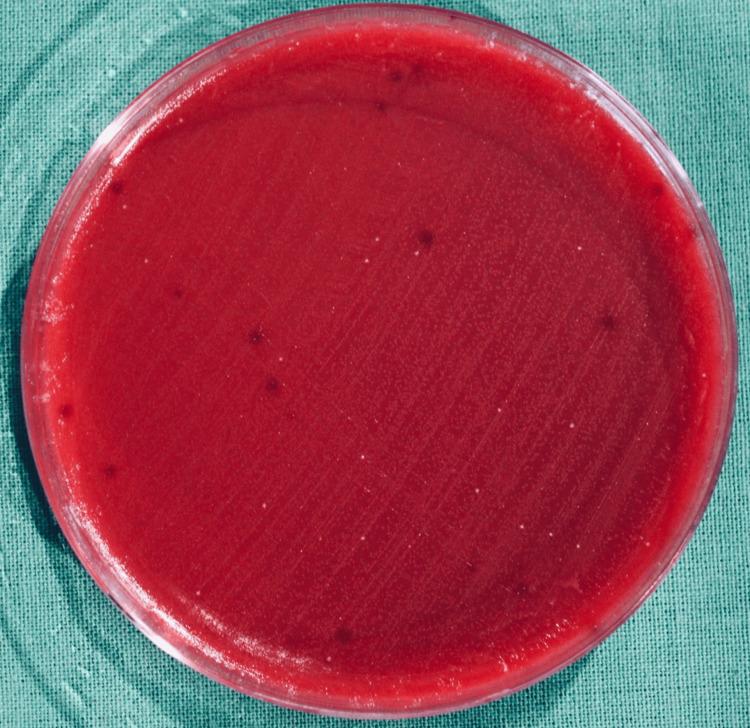
https://cdn.ncbi.nlm.nih.gov/pmc/blobs/78d4/10733898/cc0a1d1cb6d6/cureus-0015-00000049164-i07.jpg
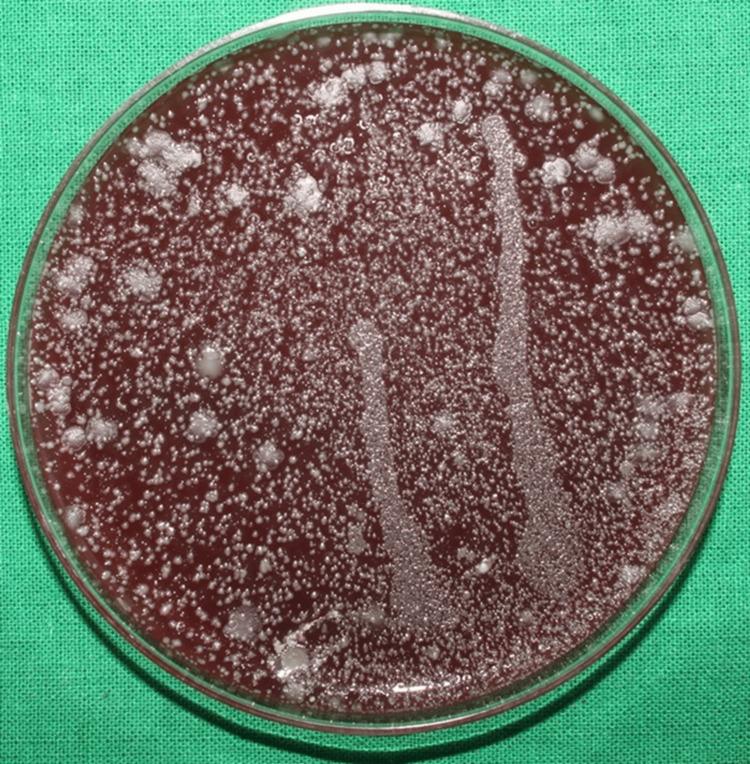
https://cdn.ncbi.nlm.nih.gov/pmc/blobs/78d4/10733898/e8bcbc2791e3/cureus-0015-00000049164-i04.jpg

富氧漱口水作为超声洁治术前口腔冲洗剂对抗超声洁治过程中产生的口腔微生物的疗效。
Efficacy of Oxygen-Enriched Mouthwash as a Pre-procedural Mouth Rinse Against Oral Microbes Produced During Ultrasonic Scaling.
作者信息
Sindhusha Vyshnavi B, Rajasekar Arvina
机构信息
Periodontics, Saveetha Dental College and Hospitals, Saveetha Institute of Medical and Technical Sciences, Saveetha University, Chennai, IND.
出版信息
Cureus. 2023 Nov 21;15(11):e49164. doi: 10.7759/cureus.49164. eCollection 2023 Nov.
Aim Oxygen-enriched mouthwash products are based on oral topical oxygen therapy (OOT), which supports the formation of new blood vessels and the removal of toxins and waste products from the affected area and stimulates the synthesis of collagen. These antioxidant mouthwashes contain honey, lactoferrin, and sodium carbonate peroxide. Lactoferrin is an anti-inflammatory protein that binds the ferrous iron ions surrounding micro-organisms regulating bacterial growth. Hence, these products can be included as an adjunct to toothbrushing after oral surgeries and in the treatment of conditions like gingival inflammation and peri-implantitis. The aim of the study was to evaluate the efficacy of oxygen-enriched mouthwash as a pre-procedural mouth rinse against oral microbes in the aerosol produced during ultrasonic scaling. Materials and methods A total of 40 patients with an age range of 20-40 years who have been advised to undergo ultrasonic scaling were selected as study subjects and were randomly allocated to group 1 (test group; n = 20; blue®m mouthwash) and group 2 (control group; n = 20; chlorhexidine). After evaluating the initial bacterial load after the use of water (placebo) as pre-rinse on the patient's chest and shoulder areas in both experimental and control groups, both the group subjects were instructed to gargle with 10 ml of the provided mouth rinse for one minute before ultrasonic scaling procedure. Blood agar plates were placed at the patient's chest and shoulder area to collect the aerosol and were later incubated to assess the colony-forming units (CFUs). An independent t-test was done to compare the CFUs between the groups. Results The mean initial bacterial load after the use of water (placebo) as pre-rinse on the patients' chest area (122.4 ± 0.6) and shoulder area (109.3 ± 2.6) in the experimental group was similar to the bacterial load seen on the chest area (126.2 ± 4.8) and shoulder area (115.4 ± 3.8) in the control group. The CFUs found in blood agar plates placed on the chest (59.8 ± 2.5) and shoulder (35.3 ± 3.6) areas of patients in group 1 were less as compared to CFUs found in blood agar plates placed on the chest (104.8 ± 3.2) and shoulder (75.3 ± 2.8) areas of patients in group 2. The difference between both groups was statistically significant with a p-value of ≤0.05. Conclusion There is a reduction in the bacterial load in the aerosols that are emitted during the ultrasonic scaling procedure with the use of oxygen-enriched mouthwash as a pre-procedural rinse when compared with chlorhexidine.
目的 富氧漱口水产品基于口腔局部氧疗(OOT),该疗法有助于新血管的形成以及毒素和废物从患处的清除,并刺激胶原蛋白的合成。这些抗氧化漱口水含有蜂蜜、乳铁蛋白和过碳酸钠。乳铁蛋白是一种抗炎蛋白,它结合微生物周围的亚铁离子以调节细菌生长。因此,这些产品可作为口腔手术后刷牙的辅助手段,并用于治疗牙龈炎症和种植体周围炎等病症。本研究的目的是评估富氧漱口水作为术前漱口液对超声洁治过程中产生的气溶胶中的口腔微生物的疗效。
材料和方法 总共选择了40名年龄在20至40岁之间且已被建议进行超声洁治的患者作为研究对象,并将他们随机分为第1组(试验组;n = 20;blue®m漱口水)和第组2(对照组;n = 20;氯己定)。在试验组和对照组中,以水(安慰剂)作为术前漱口液使用后,在患者胸部和肩部区域评估初始细菌载量后,指示两组受试者在超声洁治程序前用10毫升提供的漱口水漱口1分钟。将血琼脂平板放置在患者的胸部和肩部区域以收集气溶胶,随后进行培养以评估菌落形成单位(CFU)。进行独立t检验以比较两组之间的CFU。
结果 在试验组中,以水(安慰剂)作为术前漱口液使用后,患者胸部区域(122.4 ± 0.6)和肩部区域(109.3 ± 2.6)的平均初始细菌载量与对照组中胸部区域(126.2 ± 4.8)和肩部区域(11 = 5.4 ± 3.8)的细菌载量相似。与第2组患者胸部(10 = 4.8 ± 3.2)和肩部(75.3 ± 2.8)区域的血琼脂平板中发现的CFU相比,第1组患者胸部(59.8 ± 2.5)和肩部(35 = 3 ± 3.6)区域的血琼脂平板中发现的CFU较少。两组之间的差异具有统计学意义,p值≤0.05。
结论 与氯己定相比,使用富氧漱口水作为术前漱口液时,超声洁治过程中产生的气溶胶中的细菌载量会降低。